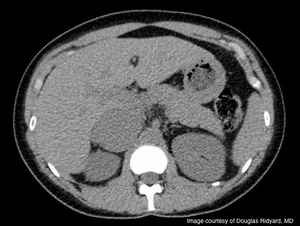
Challenging case: A young woman presenting with rapid weight gain

An 18-year-old previously healthy collegiate athlete presented to the emergency room with a rapid weight gain of 20 pounds during the previous 2 months. She complained of significant fatigue and irregular menstrual periods.
Published: July 25th 2018 | Updated: